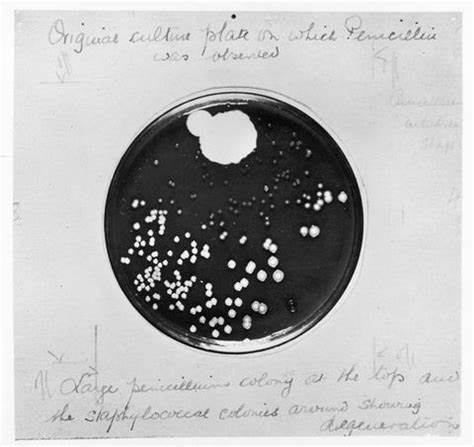
Placa de Petri de Fleming, amb notes escrites per ell, on hi havia crescut un fong (part superior). En la resta, es veuen múltiples colònies d'estafilococs (punts blancs). Les que queden al voltant del fong són molt petites i són en nombre menor.

L’hospital St. Mary’s va ser inaugurat el 1851 per decisió del consell parroquial del poble de Paddington, en constatar que el creixement demogràfic que havia facilitat l’arribada del ferrocarril de la companyia Great Western Railway (1837) i la construcció del Grand Junction Canal (1805) havia generat més necessitats sanitàries (Fig.1).

La decisió va ser construir un hospital de beneficència en el que treballarien els metges voluntàriament, sense cobrar, amb la possibilitat de donar classes a l’escola de medicina que es crearia associada a l’hospital. El prestigi de ser professor universitari compensava treballar gratuïtament com a metge d’hospital, a més de l’enriquiment professional, en quant a coneixements i experiència, que comportava el treballar en companyia de col·legues. L’hospital, que s’inaugura el 1851, té 150 llits.
El treball de les infermeres i llevadores es professionalitza el 1876, quan arriba a l’hospital per dirigir les infermeres la sra. Rachel Williams, protegida de Florence Nightingale.
En arribar la Primera Guerra Mundial, es constata una gran reducció del nombre d’estudiants, ja que la gran majoria s’han allistat a l’exèrcit. El 1916, es decideix acceptar les noies que estudiaven a la London School of Medicine for women. No obstant, la primera doctora que fou cap de servei no va ser contractada fins 1971.
El St. Mary’s Hospital va absorbir, el 1944, diversos hospitals locals petits del barri, com el Samaritan Hospital, que era només per dones, el Paddington General Hospital i el Western Eye Hospital (Fig.2). L’any 1997 s’integra amb el Charing Cross Hospital i la Westminster Medical School per formar l’Imperial College School of Medicine.

Els dos primers estudiants foren admesos a l’escola de medicina el 1851, però l’escola no obre les portes fins tres anys més tard.

El 1928, en un laboratori del servei del professor sir Almroth Wright, hi treballava el Dr. Alexander Fleming (Fig.4), que va descobrir la penicil·lina de manera casual quan tornava de vacances (veure aquesta entrada del blog de 30/6/22). Aquest petit laboratori està convertit en el Museu Alexander Fleming, la visita del qual és molt recomanable.

Havia deixat, abans de marxar, plaques de Petri on hi havia sembrat estafilococs. En tornar, s’adona que alguna placa estava contaminada per un fong, Penicillium notatum, i que al voltant seu havien desaparegut els estafilococs, suposadament perquè alguna substància produïda pels fongs, que ell va denominar penicil·lina, tenia capacitat bactericida (Fig.5).
Fleming va comunicar el seu descobriment sobre la penicil·lina al British Journal of Experimental Pathology el 1929. Va treballar durant un temps tractant d’obtenir penicil·lina purificada a partir dels cultius de Penicillium notatum, però no va tenir èxit i va abandonar vels seus intents.
Fleming era un assistent del professor sir Almroth Wright (1861 – 1947) (Fig.5), bacteriòleg i immunòleg, nominat 14 cops pel premi Nobel des de 1906 fins 1925, que va destacar per desenvolupar una vacuna antitifoide (veure aquesta entrada del blog de 23/7/21). Wright, que era el catedràtic de bacteriologia, delegà en Fleming la docència de l’assignatura.
Referències
EA Heaman. St. Mary’s ; the History of a London teaching hospital. J R Soc Med., 2004; 97 (8): 405 – 406.
Walker, N M (2007), “Edward Almroth Wright”, Journal of the Royal Army Medical Corps. 2007; 153 (1) : 16–17.